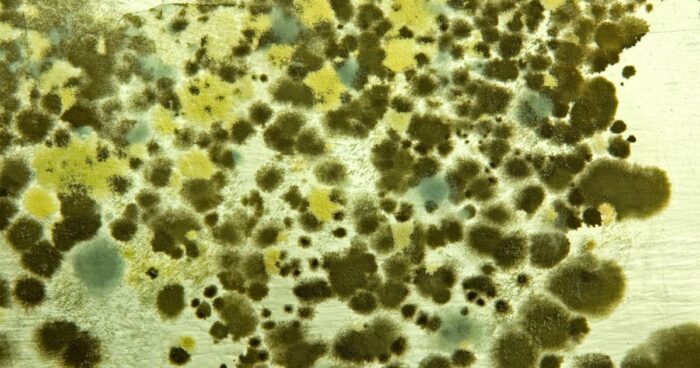
The most common types of moulds are yeast mould, black mould, green mould and penicillin mould.

Mould is an unpleasant problem that can affect our homes. Several species of these microscopic fungi can have a negative effect on our health. In this article, we’ll look at why moulds form, what they cause and how to get rid of them.

Obsah
How does mould form?
Mould arises from microscopic spores that are airborne. When these spores find a suitable environment, they begin to reproduce and form colonies. Moulds need moisture and organic material such as wood, paper, textiles or food to grow. When these materials combine with moisture, they create ideal conditions for mould to live.
Mould can appear as in the home as well as outside. Indoors, they are found in places with excessive humidity, where the temperature is around 25 °C. These are most often bathrooms, kitchens, cellars or places where water leaks in. Outside, mould can affect plants, trees or building facades.
Learn how to reduce humidity in the apartment.
Types of mould you may encounter
The most common types of moulds include:
- Yeast mould – A white or creamy mould that is often found on foods such as bread, fruit or dairy products. It can appear on bathroom walls and other damp places.
- Black mould – One of the most well-known mould species, black mould is dark to black in colour and is often found in damp or musty places (bathrooms, kitchens, cellars). Black mold can have a negative effect not only on the air quality, but also on the health of the home’s occupants.
- Green mould – This mould usually appears on walls or grass. It has a light green colour and is caused by high humidity, excessive rain or insufficient sunlight.
- Intestinal mould – Intestinal mould, also known as penicillin mould, is used in medicine to produce antibiotics. It is found in agricultural soil, on food or plants.
What causes mould?
The presence of mould in your home or work environment can negatively affect your health. Fungi produce microscopic particles that can be inhaled into the lungs. This can lead to respiratory problems and worsen existing breathing problems such as asthma. Some species of mould also produce toxins that are very harmful.
Symptoms of mold exposure
If you are exposed to mould, you may experience a variety of symptoms. Among the most common are allergic reactions, which take the form of sneezing, itchy eyes and nose, runny nose or skin rashes. Some people may even experience more serious problems.
The cause of these problems is usually a specific odour which, together with increased humidity, deteriorates the air quality in the room. It is therefore very important not only to notice the stains on the walls, but also to observe yourself and to deal with the mould in time.
How to prevent mould?
Prevention is a key factor in avoiding mould. Below we have 6 tips for you to prevent the formation and spread of mould:
- Maintain the right level of humidity in the house. Use dehumidifiers that precipitate moisture and create unsuitable conditions for mould life.
- Ventilate the bathroom and kitchen regularly. Open the window and air out after every bath or cooking session.
- Repair any leaks in windows, doors and the roof that may be causing moisture to enter the house.
- Use a photocatalytic coating on the façade. It prevents mould from settling and growing.
- Clean your home regularly. Thoroughly clean all areas that are susceptible to mould (showers, kitchens and cellars).
- For major mould problems, don’t be afraid to contact a professional. They will reveal where your mould is hiding and give you advice on how to beat it.

You might be interested in: Thorough household cleaning: tips to get rid of allergens
How to remove mold?
If you have found mould in your home, it is important to remove it as soon as possible. You should take the following steps:
- Identify the source of the mould – Find out where the mould is and what is causing it to spread. This may be due to e.g. moisture, leaking windows or roof.
- Reduce humidity – Ensure rooms are well ventilated and maintain the correct humidity levels. Consider using dehumidifiers to get rid not only of mould but also musty smells, protect furniture and reduce pests.
- Remove affected materials – If mould is present on the surface of materials such as wallpaper or flooring, it is best to remove these materials and replace them with new ones. This is the only way to prevent the further spread of mould.
- Use mould removers – There are many mould removers on the market. Always follow the manufacturer’s instructions when using them. When applying them to the affected areas, be in a well-ventilated area and use protective equipment such as gloves and respirator.
- Get an ozone air purifier – After mold removal, it’s important to clean the air thoroughly. Everything will be taken care of ozone generator which you should use regularly from now on.
- Watch out for recurring mould – If mould returns to the same spot regularly, it could be a sign of a bigger problem. In such a case, it is advisable to contact a specialist to find out the cause and suggest a suitable solution.

Learn how to choose the best dehumidifier.
What to take away from the article?
Mould can make our lives pretty unpleasant. Whether mould is found in the home, workplace or outside of buildings, it is important not to overlook the problem. Take care to prevent or get rid of mould as soon as possible to minimise its negative impact on your health and that of your loved ones.
Frequently Asked Questions
Where does mould thrive?
Mould is found in damp places. You will often find them in the bathroom by the shower, kitchen or windows.
How does mold spread?
Fungi are spread by spores that are airborne. They occur not only outside but also inside the home.
What causes mould?
Mould can lead to allergic reactions such as a runny nose, itchy eyes or a rash. They can also cause serious respiratory problems, especially in asthmatics.
How to prevent mould?
The most important thing is to get rid of moisture in the home, which will help you
a dehumidifier
. It is not a bad thing to acquire
ozone generator
to remove any mould growth. Also make sure you have regular but vigorous ventilation and household cleaning.